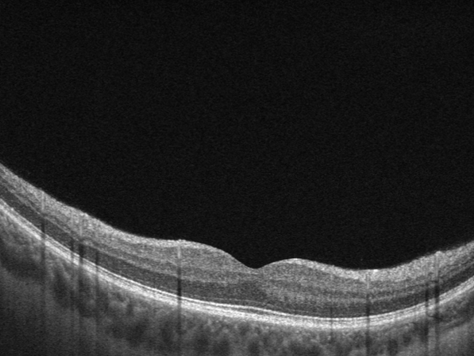
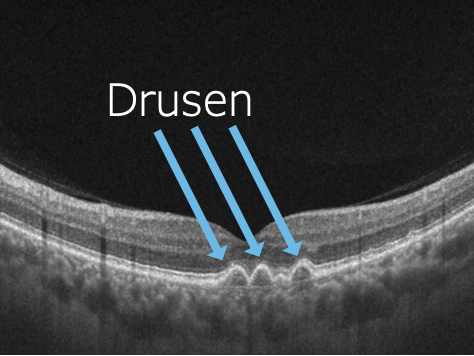

Patienteninfo
Altersbedingte Makula-Degeneration AMD
„Der grösste Risikofaktor der AMD ist das Alter. Die Erkrankung kann ab einem Alter von 50 Jahren und mit zunehmendem Alter mit steigender Wahrscheinlichkeit auftreten.
Es folgt eine schmerzfreie, fortschreitende Schädigung des Netzhautzentrums mit unterschiedlichen Ausprägungen und Schweregraden. Die Sehstörungen werden individuell wahrgenommen.“
Es gibt zwei Formen der AMD, die trockene und die feuchte Form. Die Krankheiten unterscheiden sich im Fortschreiten und in der Therapie. Je früher eine Therapie begonnen wrid, desto erfolgreicher kann diese auch ausfallen.

Feuchte AMD

Trockene AMD
AMD – was steckt dahinter?
Die wenige Quadratmilimeter grosse Makula hat einen ausgesprochen aktiven Soffwechsel. Die Entsorgung der Stoffwechselprodukte läuft über das Pigmentepithel unter der Makula. Mit zunehmendem Alter funktioniert der Stoffwechsel nicht immer einwandfrei und es kommt zu Ablagerungen unter der Netzhaut, sogenannte Drusen.
Symptome einer AMD
Die AMD beginnt meist symtptomfrei. Selbst wenn ein Auge schon betroffen ist, sorgt das andere für einen Ausgleich. Die Beschwerden nehmen im späteren Stadium deutlich zu und beeinträchtigen im Alltag stark.
Typische Symptome sind:
- erhöhter Lichtbedarf tagsüber
- verstärkte Blendempfindlichkeit
- verminderte Farb- und Kontrastwahrnehmung
- verzerrtes Sehen
- verminderte zentrale Sehschärfe
- grauer/dunkler Fleck
Risikofaktoren für eine AMD
Nur gewisse Risikofaktoren können beeinflusst werden. Heute bekannt sind unter anderem folgende Risikofaktoren.
- Beeinflussbare: Sonnenstrahlung, Rauchen
- Nicht beeinflussbare: Alter, Bereits ein betroffenes Auge, Genetik
Diagnose
Um eine AMD zu diagnostizieren ist ein Besuch bei einem Augenarzt oder Optometristen nötig. Die Untersuchungen erfolgen schmerzfrei. Die Diagnose geschieht einerseits mit dem Mikroskop, andererseits mittels OCT (Optischer Kohärenztomographie).
Gesunde Makula
Trockene AMD

Feuchte AMD
Behandlung
Die AMD ist eine chronisch verlaufende Erkrankung. Eine Heilung der Erkrankung ist bislang nicht möglich, ein Hinauszögern der Erkrankung und somit ein längerer Erhalt der Lebensqualität ist meistens möglich.
Behandlung der trockenen AMD
Für die Therapie der trockenen AMD stehen grundsätzlich zwei Therapieoptionen zur Verfügung. Die beste Therapiewirkung ist zu erwarten, wenn beide Therapien kombiniert eingesetzt werden.
Seit längerem ist bekannt, dass Nahrungsergänzung mit Lutein und Zeaxanthin beim Abbau der in den Drusen enthaltenen Abfallstoffen hilft. Ein etwa 25% langsamerer Verlauf der Erkrankung kann durch die tägliche Einnahme der Nahrungsergänzung erzielt werden.
Die neuere Therapie mittels Photobiomodulation bewirkt eine Reduktion der Drusen und führt langfristig ebenfalls zu einem weniger schnellen Verlauf der Erkrankung. Die Photobiomodulation wird alle 4-6 Monate durchgeführt. Ein Therapiezyklus enthält 9 Zyklen à ca. 5-10 Minuten innert 3-5 Wochen. Dies ist eine berührungsfreie Therapie mittels Lichtimpulsen; Nebenwirkungen sind nur kurzzeitig: veränderte Lichtwahrnehmung und gleich nach der Therapie allenfalls leicht trockene Augen.
Beide Therapien sind nicht kassenpflichtig und müssen durch den Patienten selbst bezahlt werden.
Behandlung der feuchten AMD
Liegt eine feuchte AMD vor, wird dringend empfohlen mit Injektionen direkt ins Auge die Gefässneubildung zu hemmen. Ohne diese Therapie ist ein sehr rasches Fortschreiten der Erkrankung mit massivem und permanentem Sehverlust zu erwarten.
Selbstkontrolle
Das sogenannte Amsler-Gitter hier auf der rechten Seite dient zur regelmässigen Selbstkontrolle.

Anwendung:
- Falls Sie eine Brille oder Kontaktlinsen brauchen, benutzen Sie diese für den Test
- Halten Sie den Test auf Lesedistanz
- Halten Sie ein Auge mit der Hand zu
- Fixieren Sie den schwarzen Punkt in der Mitte
- Beurteilen Sie nun, wie die Linien rund um den schwarzen Punkt aussehen:
- Sehen sie verzerrte, verbogene oder verschwommene Linien?
- Erscheinen Ihnen die Linien unterbrochen oder fehlen diese ganz?
Ist Ihnen die Veränderung nicht bekannt oder tritt sie neu oder verstärkt auf, suchen Sie einen Augenarzt auf.
- Wiederholen Sie den Test mit dem anderen Auge
- Führen Sie den Test 1x/Woche durch